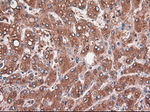
CPA1 (Carboxypeptidase A1) Antibody in Immunohistochemistry (Paraffin) (IHC (P))

Search
OriGene
CPA1 (Carboxypeptidase A1) Monoclonal Antibody (OTI2A3), TrueMAB™
{{$productOrderCtrl.translations['antibody.pdp.commerceCard.promotion.promotions']}}
{{$productOrderCtrl.translations['antibody.pdp.commerceCard.promotion.viewpromo']}}
{{$productOrderCtrl.translations['antibody.pdp.commerceCard.promotion.promocode']}}: {{promo.promoCode}} {{promo.promoTitle}} {{promo.promoDescription}}. {{$productOrderCtrl.translations['antibody.pdp.commerceCard.promotion.learnmore']}}
产品信息
CF500053
宿主/亚型
分类
类型
克隆号
抗原
偶联物
形式
浓度
规格
保存条件
运输条件
产品详细信息
For reconstitution, we recommend adding 100 µL distilled water to a final antibody concentration of about 1 mg/mL. To use this carrier-free antibody for conjugation experiments, we strongly recommend performing another round of desalting. (Zeba Spin Desalting Columns, 7KMWCO, 0.5 mL, Product # 89882)
靶标信息
CPA1, also known as CPA, is a 419 amino acid secreted monomeric protein that is highly expressed in pancreatic tissue. Functioning as a pancreatic exopeptidase, CPA1 uses zinc as a cofactor to catalyze the release of C-terminal amino acids from a variety of proteins, thereby playing a key role in protein digestion and degradation. Via its catalytic activity, CPA1 is also thought to be involved in zymogen (proenzyme) inhibition, probably functioning to block enzyme activation pathways. Abnormal levels of CPA1 are associated with pancreatic cancer, suggesting a possible role in either tumor progression or tumor suppression events.
仅用于科研。不用于诊断过程。未经明确授权不得转售。